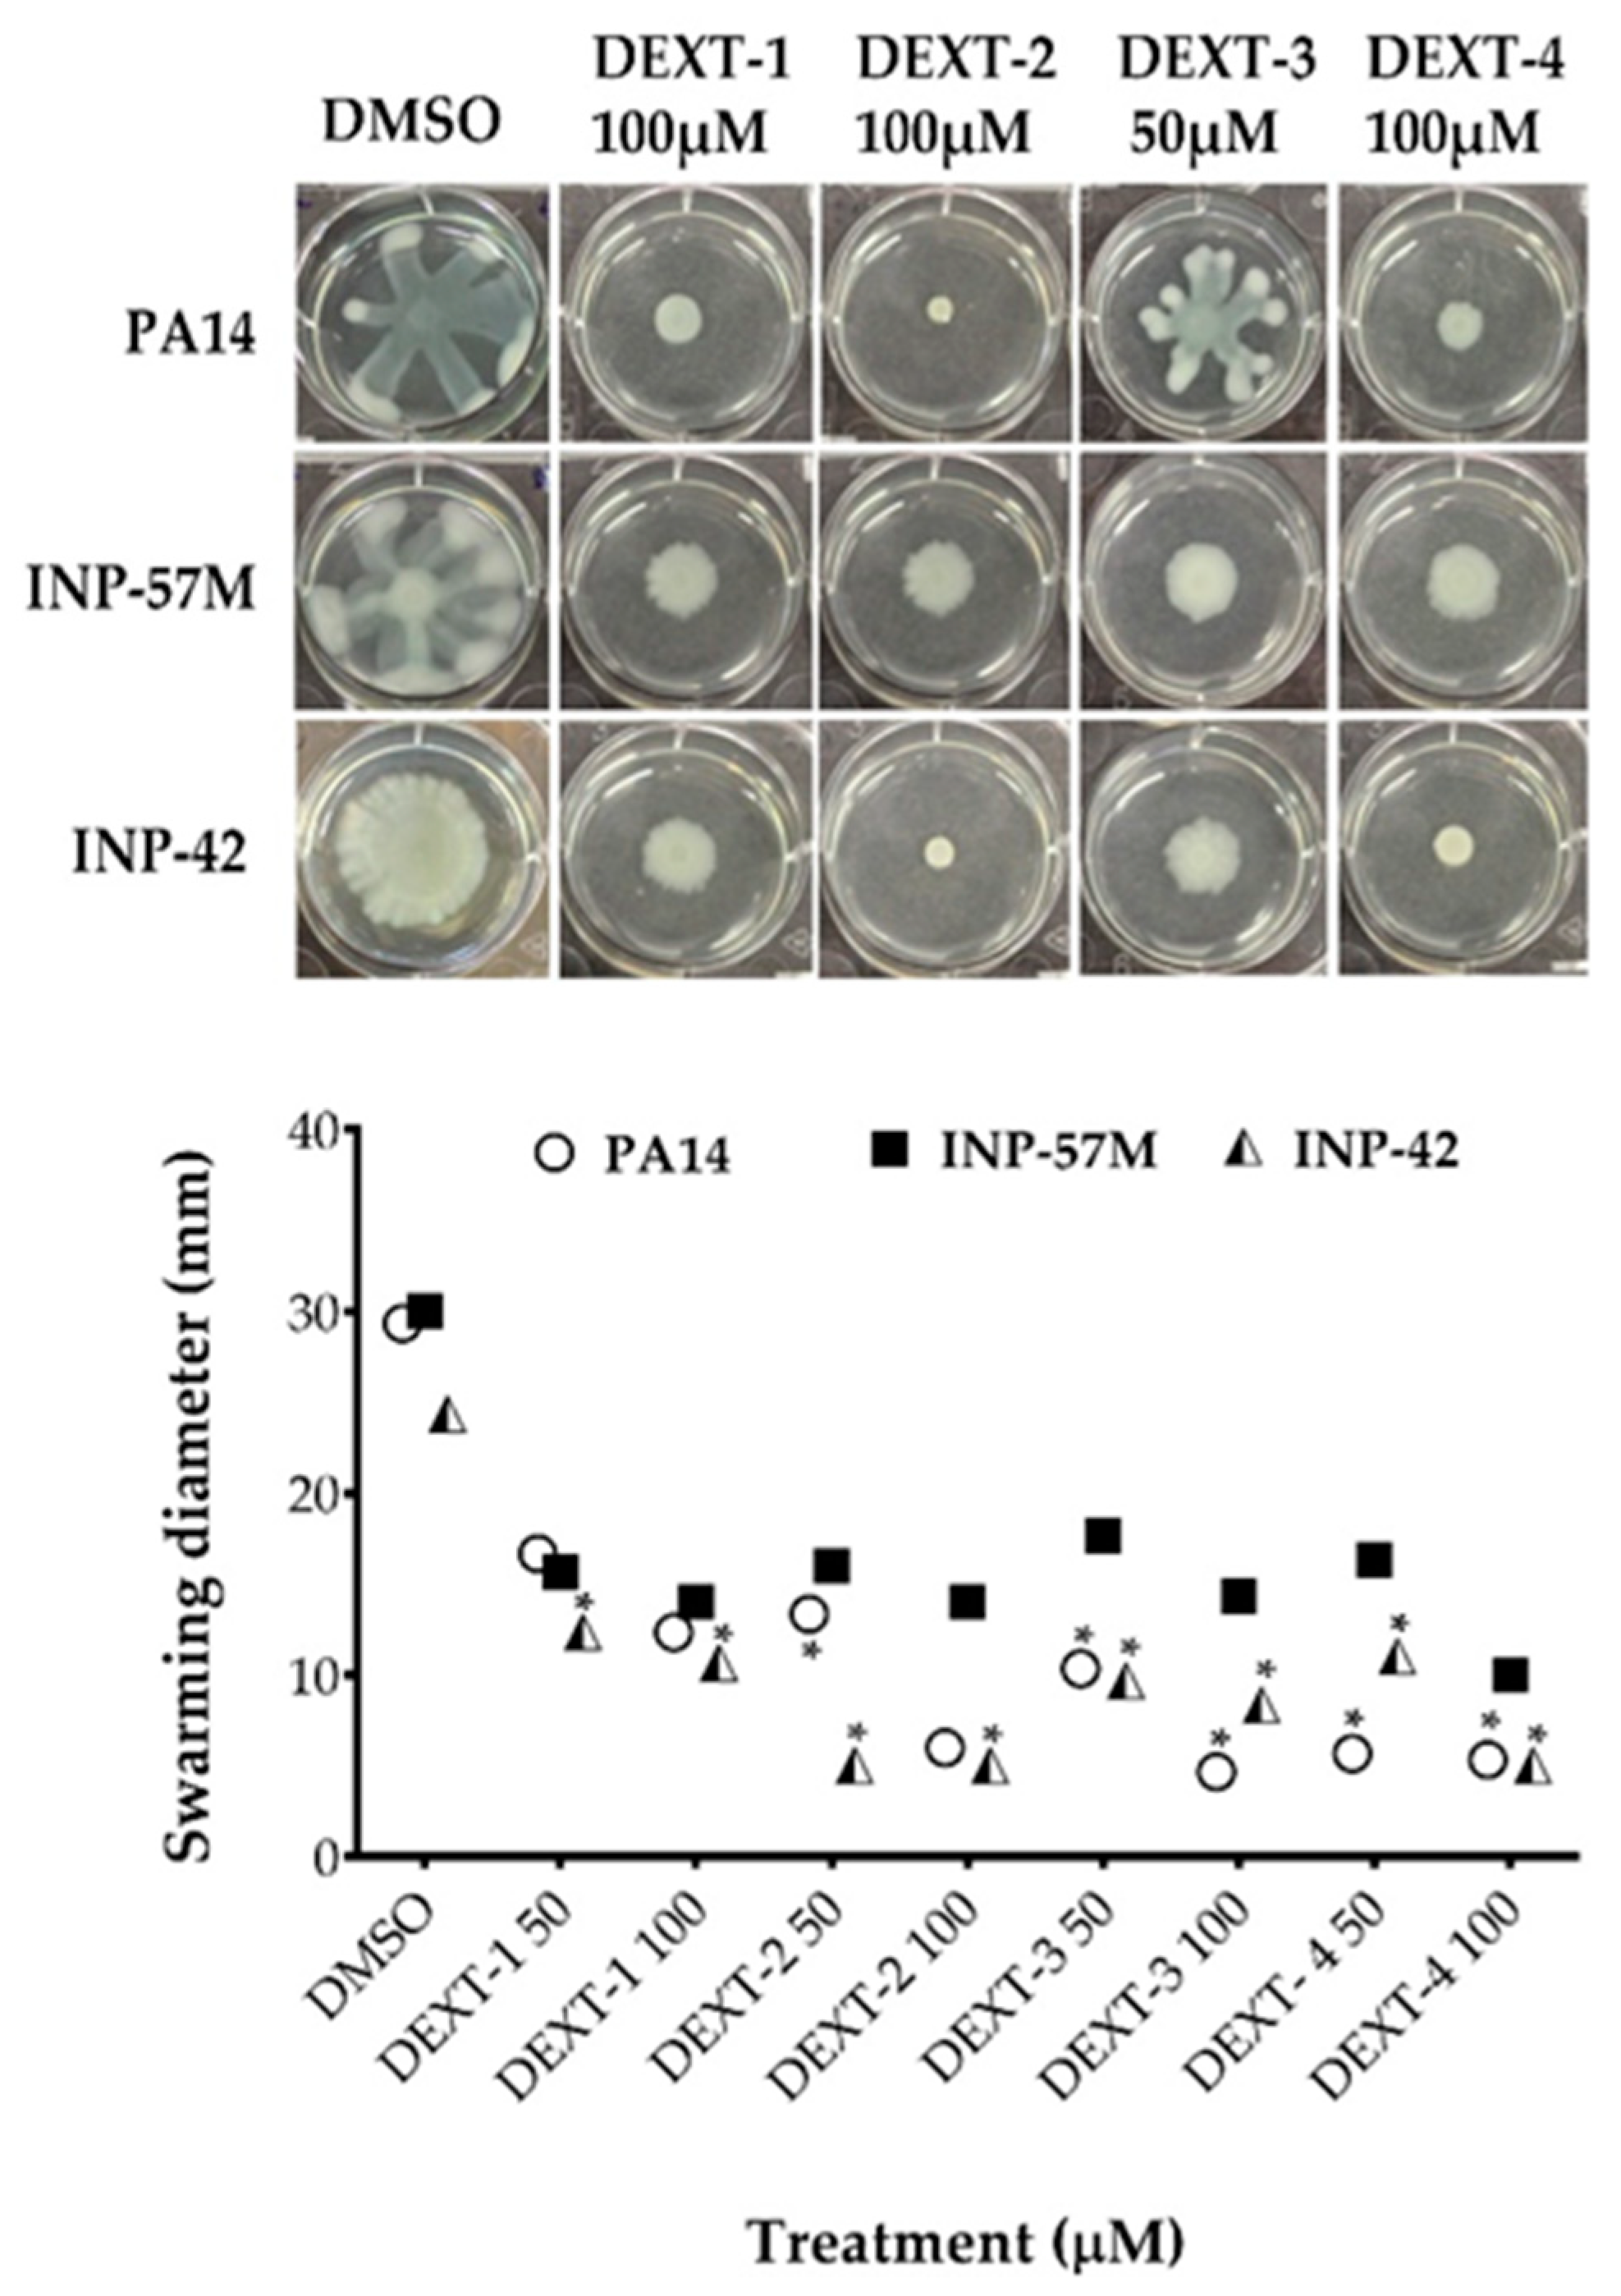

Anti-Pathogenic Properties of the Combination of a T3SS Inhibitory Halogenated Pyrrolidone with C-30 Furanone
Abstract
:1. Introduction
2. Results
2.1. Synthesis of Halogen Pyrrolidones (DEXT)
2.2. Anti-Virulence Properties of Halogenated Pyrrolidones
2.3. Inhibition of Type III Effector Secretion by Halogenated Pyrrolidones
2.4. DEXT-3 Antipathogenic Activity in a Murine Infection Model
3. Discussion
4. Conclusions
5. Materials and Methods
5.1. Synthesis of Pyrrolidones DEXT 1–4
5.2. Crystal Data for DEXT-2
5.3. Bacterial Growth in the Presence of DEXT 1–4
5.4. Inhibition of Virulence Factors
5.4.1. P. aeruginosa Biofilm Formation
5.4.2. Swarming Motility
5.5. Type III Secretion Assay
5.6. Mouse Necrosis Model
5.7. Ethical Declaration
Supplementary Materials
Author Contributions
Funding
Institutional Review Board Statement
Informed Consent Statement
Data Availability Statement
Acknowledgments
Conflicts of Interest
Sample Availability
References
- World Health Organization. Media Centre. WHO Publishes List of Bacteria for Which New Antibiotics Are Urgently Needed 27 February 2017. Available online: https://www.who.int/mediacentre/news/releases/2017/bacteria-antibiotics-needed/en/ (accessed on 6 November 2021).
- Aguilar-Rodea, P.; Zúñiga, G.; Rodríguez-Espino, B.A.; Olivares Cervantes, A.L.; Gamiño Arroyo, A.E.; Moreno-Espinosa, S.; de la Rosa Zamboni, D.; López Martínez, B.; Castellanos-Cruz, M.D.; Parra-Ortega, I.; et al. Identification of extensive drug resistant Pseudomonas aeruginosa strains: New clone ST1725 and high-risk clone ST233. PLoS ONE 2017, 12, e0172882. [Google Scholar] [CrossRef] [Green Version]
- Castillo-Juárez, I.; Maeda, T.; Mandujano-Tinoco, E.A.; Tomás, M.; Pérez-Eretza, B.; García-Contreras, S.J.; Wood, T.K.; García-Contreras, R. Role of quorum sensing in bacterial infections. World J. Clin. Cases 2015, 3, 575–598. [Google Scholar] [CrossRef] [PubMed]
- Sakr, M.M.; Elkhatib, W.F.; Aboshanab, K.M.; Mantawy, E.M.; Yassien, M.A.; Hassouna, N.A. In vivo evaluation of a recombinant N-acylhomoserine lactonase formulated in a hydrogel using a murine model infected with MDR Pseudomonas aeruginosa clinical isolate, CCASUP2. AMB Express 2021, 11, 109. [Google Scholar] [CrossRef]
- Hemmati, F.; Salehi, R.; Ghotaslou, R.; Samadi Kafil, H.; Hasani, A.; Gholizadeh, P.; Nouri, R.; Ahangarzadeh Rezaee, M. Quorum quenching: A potential target for antipseudomonal therapy. Infect. Drug Resist. 2020, 13, 2989–3005. [Google Scholar] [CrossRef]
- Defoirdt, T.; Brackman, G.; Coenye, T. Quorum sensing inhibitors: How strong is the evidence? Trends Microbiol. 2013, 21, 619–624. [Google Scholar] [CrossRef] [PubMed]
- Allen, R.C.; Popat, R.; Diggle, S.P.; Brown, S.P. Targeting virulence: Can we make evolution-proof drugs? Nat. Rev. Microbiol. 2014, 12, 300–308. [Google Scholar] [CrossRef] [PubMed]
- Mirzaei, R.; Mohammadzadeh, R.; Alikhani, M.Y.; Shokri Moghadam, M.; Karampoor, S.; Kazemi, S.; Barfipoursalar, A.; Yousefimashouf, R. The biofilm-associated bacterial infections unrelated to indwelling devices. IUBMB Life 2020, 72, 1271–1285. [Google Scholar] [CrossRef]
- Hentzer, M.; Wu, H.; Andersen, J.B.; Riedel, K.; Rasmussen, T.B.; Bagge, N.; Kumar, N.; Schembri, M.A.; Song, Z.; Kristoffersen, P.; et al. Attenuation of Pseudomonas aeruginosa virulence by quorum sensing inhibitors. EMBO J. 2003, 22, 3803–3815. [Google Scholar] [CrossRef]
- Wu, H.; Song, Z.; Hentzer, M.; Andersen, J.B.; Molin, S.; Givskov, M.; Høiby, N. Synthetic furanones inhibit quorum-sensing and enhance bacterial clearance in Pseudomonas aeruginosa lung infection in mice. J. Antimicrob. Chemother. 2004, 53, 1054–1061. [Google Scholar] [CrossRef] [Green Version]
- Garcia-Contreras, R.; Perez-Eretza, B.; Jasso-Chavez, R.; Lira-Silva, E.; Roldan-Sanchez, J.A.; Gonzalez-Valdez, A.; Soberon-Chavez, G.; Coria-Jimenez, R.; Martinez-Vazquez, M.; Alcaraz, L.D.; et al. High variability in quorum quenching and growth inhibition by furanone C-30 in Pseudomonas aeruginosa clinical isolates from cystic fibrosis patients. Pathog. Dis. 2015, 73, ftv040. [Google Scholar] [CrossRef] [PubMed] [Green Version]
- Lombardi, C.; Tolchard, J.; Bouillot, S.; Signor, L.; Gebus, C.; Liebl, D.; Fenel, D.; Teulon, J.-M.; Brock, J.; Habenstein, B.; et al. Structural and functional characterization of the Type Three Secretion System (T3SS) needle of Pseudomonas aeruginosa. Front. Microbiol. 2019, 10, 573. [Google Scholar] [CrossRef] [PubMed] [Green Version]
- Pena, R.T.; Blasco, L.; Ambroa, A.; González-Pedrajo, B.; Fernández-García, L.; López, M.; Bleriot, I.; Bou, G.; García-Contreras, R.; Wood, T.K.; et al. Relationship between quorum sensing and secretion systems. Front. Microbiol. 2019, 10, 1100. [Google Scholar] [CrossRef] [PubMed] [Green Version]
- Lee, V.T.; Smith, R.S.; Tümmler, B.; Lory, S. Activities of Pseudomonas aeruginosa effectors secreted by the Type III secretion system in vitro and during infection. Infect. Immun. 2005, 73, 1695–1705. [Google Scholar] [CrossRef] [Green Version]
- Shorvon, S. Pyrrolidone derivatives. Lancet 2001, 358, 1885–1892. [Google Scholar] [CrossRef]
- Sangnoi, Y.; Plubrukarn, A.; Arunpairojana, V.; Kanjana-Opas, A. A new antibacterial amino phenyl pyrrolidone derivative from a novel marine gliding bacterium Rapidithrix thailandica. World J. Microbiol. Biotechnol. 2014, 30, 1135–1139. [Google Scholar] [CrossRef]
- Wang, J.; Yao, Q.F.; Amin, M.; Nong, X.H.; Zhang, X.Y.; Qi, S.H. Penicillenols from a deep-sea fungus Aspergillus restrictus inhibit Candida albicans biofilm formation and hyphal growth. J. Antibiot. 2017, 70, 763–770. [Google Scholar] [CrossRef] [Green Version]
- Gaudernak, E.; Seipelt, J.; Triendl, A.; Grassauer, A.; Kuechler, E. Antiviral effects of pyrrolidine dithiocarbamate on human rhinoviruses. J. Virol. 2002, 76, 6004–6015. [Google Scholar] [CrossRef] [Green Version]
- Castro-Torres, V.A.; Jacobo-Herrera, N.J.; Díaz-Sánchez, L.; Rocha-Zavaleta, L.; García-López, P.; Martínez-Vázquez, M. Synthesis and cytotoxic evaluation of halogenated furanones. Monatsh. Chem. 2020, 151, 1841–1849. [Google Scholar] [CrossRef]
- Narayana Murthy, S.; Madhav, B.; Vijay Kumar, A.; Rama Rao, K.; Nageswar, Y.V.D. Facile and efficient synthesis of 3,4,5-substituted furan-2(5H)-ones by using β-cyclodextrin as reusable catalyst. Tetrahedron 2009, 65, 5251–5256. [Google Scholar] [CrossRef]
- Swamy, M.; Venkatesh, N.; Swapna, M.; Rao, P. Microwave assisted synthesis and antimicrobial activity of substituted pyrrolidinone derivatives. Int. J. ChemTech Res. 2020, 13, 227–231. [Google Scholar] [CrossRef]
- Saha, A.; Payra, S.; Banerjee, S. In-water facile synthesis of poly-substituted 6-arylamino pyridines and 2-pyrrolidone derivatives using tetragonal nano-ZrO2 as reusable catalyst. RSC Adv. 2016, 6, 101953–101959. [Google Scholar] [CrossRef]
- Dutta, A.; Rohman, M.A.; Nongrum, R.; Thongni, A.; Mitra, S.; Nongkhlaw, R. Visible light-promoted synthesis of pyrrolidinone derivatives via Rose Bengal as a photoredox catalyst and their photophysical studies. New J. Chem. 2021, 45, 8136–8148. [Google Scholar] [CrossRef]
- Mondal, P.; Chatterjee, S.; Sarkar, P.; Bhaumik, A.; Mukhopadhyay, C. Preparation of DABCO-based acidic-ionic-liquid-supported ZnO nanoparticles and their application for ecofriendly synthesis of N-aryl polyhydroquinoline derivatives. ChemistrySelect 2019, 4, 11701–11710. [Google Scholar] [CrossRef]
- Hoshino, T. Violacein and related tryptophan metabolites produced by Chromobacterium violaceum: Biosynthetic mechanism and pathway for construction of violacein core. Appl. Microbiol. Biotechnol. 2011, 91, 1463–1475. [Google Scholar] [CrossRef] [PubMed]
- Coburn, B.; Sekirov, I.; Finlay, B.B. Type III secretion systems and disease. Clin. Microbiol. Rev. 2007, 20, 535–549. [Google Scholar] [CrossRef] [Green Version]
- Wolfgang, M.C.; Kulasekara, B.R.; Liang, X.; Boyd, D.; Wu, K.; Yang, Q.; Miyada, C.G.; Lory, S. Conservation of genome content and virulence determinants among clinical and environmental isolates of Pseudomonas aeruginosa. Proc. Natl. Acad. Sci. USA 2003, 100, 8484–8489. [Google Scholar] [CrossRef] [Green Version]
- Engel, J.; Balachandran, P. Role of Pseudomonas aeruginosa type III effectors in disease. Curr. Opin. Microbiol. 2009, 12, 61–66. [Google Scholar] [CrossRef]
- Liberati, N.T.; Urbach, J.M.; Miyata, S.; Lee, D.G.; Drenkard, E.; Wu, G.; Villanueva, J.; Wei, T.; Ausubel, F.M. An ordered, nonredundant library of Pseudomonas aeruginosa strain PA14 transposon insertion mutants. Proc. Natl. Acad. Sci. USA 2006, 103, 2833–2838. [Google Scholar] [CrossRef] [PubMed] [Green Version]
- Howe, T.R.; Iglewski, B.H. Isolation and characterization of alkaline protease-deficient mutants of Pseudomonas aeruginosa in vitro and in a mouse eye model. Infect. Immun. 1984, 43, 1058–1063. [Google Scholar] [CrossRef] [Green Version]
- Essar, D.W.; Eberly, L.; Hadero, A.; Crawford, I.P. Identification and characterization of genes for a second anthranilate synthase in Pseudomonas aeruginosa: Interchangeability of the two anthranilate synthases and evolutionary implications. J. Bacteriol. 1990, 172, 884–900. [Google Scholar] [CrossRef] [Green Version]
- O’Toole, G.A. Microtiter dish biofilm formation assay. J. Vis. Exp. 2011, 47, 2437. [Google Scholar] [CrossRef] [PubMed]
- Ha, D.G.; Kuchma, S.L.; O’Toole, G.A. Plate-based assay for swarming motility in Pseudomonas aeruginosa. Methods Mol. Biol. 2014, 1149, 67–72. [Google Scholar] [CrossRef] [PubMed]
- López-Jácome, L.E.; Garza-Ramos, G.; Hernández-Durán, M.; Franco-Cendejas, R.; Loarca, D.; Romero-Martínez, D.; Nguyen, P.T.D.; Maeda, T.; González-Pedrajo, B.; Díaz-Guerrero, M.; et al. AiiM lactonase strongly reduces quorum sensing controlled virulence factors in clinical strains of Pseudomonas aeruginosa isolated from burned patients. Front. Microbiol. 2019, 10, 2657. [Google Scholar] [CrossRef]
- Berube, B.J.; Murphy, K.R.; Torhan, M.C.; Bowlin, N.O.; Williams, J.D.; Bowlin, T.L.; Moir, D.T.; Hauser, A.R. Impact of type III secretion effectors and of phenoxyacetamide inhibitors of type III secretion on abscess formation in a mouse model of Pseudomonas aeruginosa infection. Antimicrob. Agents Chemother. 2017, 61, e01202-17. [Google Scholar] [CrossRef] [PubMed] [Green Version]
- Pletzer, D.; Mansour, S.C.; Wuerth, K.; Rahanjam, N.; Hancock, R.E. New mouse model for chronic infections by Gram-negative bacteria enabling the study of anti-infective efficacy and host-microbe interactions. mBio 2017, 8, e00140-17. [Google Scholar] [CrossRef] [PubMed] [Green Version]

| Entry | Reaction Time | Yield (%) | M.p. °C |
|---|---|---|---|
| 1 | 12 h | 80 | 152–153 |
| 2 | 16 h | 90 | 165–167 |
| 3 | 18 h | 85 | 144–147 |
| 4 | 12 h | 70 | 157–160 |
Publisher’s Note: MDPI stays neutral with regard to jurisdictional claims in published maps and institutional affiliations. |
© 2021 by the authors. Licensee MDPI, Basel, Switzerland. This article is an open access article distributed under the terms and conditions of the Creative Commons Attribution (CC BY) license (https://creativecommons.org/licenses/by/4.0/).
Share and Cite
Aburto-Rodríguez, N.A.; Muñoz-Cázares, N.; Castro-Torres, V.A.; González-Pedrajo, B.; Díaz-Guerrero, M.; García-Contreras, R.; Quezada, H.; Castillo-Juárez, I.; Martínez-Vázquez, M. Anti-Pathogenic Properties of the Combination of a T3SS Inhibitory Halogenated Pyrrolidone with C-30 Furanone. Molecules 2021, 26, 7635. https://doi.org/10.3390/molecules26247635
Aburto-Rodríguez NA, Muñoz-Cázares N, Castro-Torres VA, González-Pedrajo B, Díaz-Guerrero M, García-Contreras R, Quezada H, Castillo-Juárez I, Martínez-Vázquez M. Anti-Pathogenic Properties of the Combination of a T3SS Inhibitory Halogenated Pyrrolidone with C-30 Furanone. Molecules. 2021; 26(24):7635. https://doi.org/10.3390/molecules26247635
Chicago/Turabian StyleAburto-Rodríguez, Nelly Araceli, Naybi Muñoz-Cázares, Víctor Alberto Castro-Torres, Bertha González-Pedrajo, Miguel Díaz-Guerrero, Rodolfo García-Contreras, Héctor Quezada, Israel Castillo-Juárez, and Mariano Martínez-Vázquez. 2021. "Anti-Pathogenic Properties of the Combination of a T3SS Inhibitory Halogenated Pyrrolidone with C-30 Furanone" Molecules 26, no. 24: 7635. https://doi.org/10.3390/molecules26247635
APA StyleAburto-Rodríguez, N. A., Muñoz-Cázares, N., Castro-Torres, V. A., González-Pedrajo, B., Díaz-Guerrero, M., García-Contreras, R., Quezada, H., Castillo-Juárez, I., & Martínez-Vázquez, M. (2021). Anti-Pathogenic Properties of the Combination of a T3SS Inhibitory Halogenated Pyrrolidone with C-30 Furanone. Molecules, 26(24), 7635. https://doi.org/10.3390/molecules26247635

